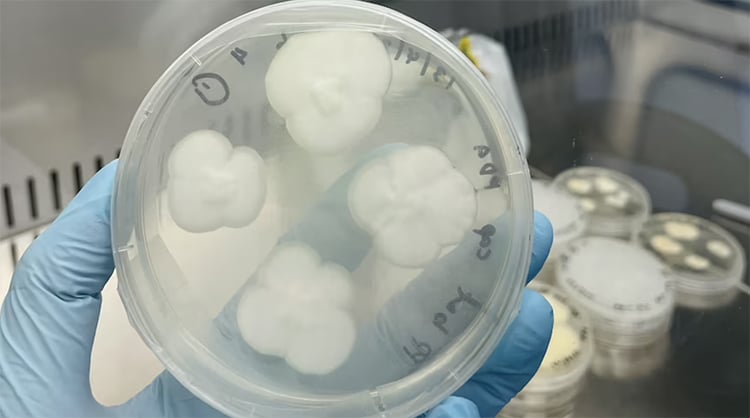

Ο πλανήτης μας έχει πρόβλημα με τη διαχείριση των πλαστικών αποβλήτων. Τα συσσωρευμένα απόβλητα και η συνεχής παραγωγή οδήγησαν σε σωρούς σκουπιδιών σε όλο τον κόσμο και ‘εκρήξεις’ στους ωκεανούς μας.
Η ανακύκλωση σαφώς και είναι ένα καλό βήμα. Το πλαστικό όμως είναι το μεγάλο πρόβλημα. Με 175 εκατομμύρια τόνους (192,9 εκατομμύρια τόνους) πλαστικού να καταλήγουν σε χώρους υγειονομικής ταφής ή ως απορρίμματα ετησίως από τους 400 εκατομμύρια τόνους (440 εκατομμύρια τόνους) που παράγονται σε όλο τον κόσμο, είναι ένα τεράστιο πρόβλημα που απασχολεί την κοινωνία εδώ και χρόνια.
Καθώς οι επιστήμονες προσπαθούν να δημιουργήσουν λύσεις για τη διάσπαση αυτού του μη βιοδιασπώμενου σκουπιδιού, μια ομάδα ερευνητών στο Πανεπιστήμιο του Σίδνεϋ ανακάλυψε δύο κοινές μορφές μυκήτων της αυλής που μπορούν να διασπάσουν πλήρως το πολυπροπυλένιο σε 140 ημέρες.
Σε μια μελέτη που δημοσιεύτηκε στο NPJ Materials Degradation, οι ερευνητές ανέλυσαν τα αποτελέσματα της χρήσης Aspergillus terreus και Engyodontium album σε πλαστικό πολυπροπυλενίου. Τα δύο είδη μυκήτων είναι κοινές μορφές μούχλας. Η ομάδα επέλεξε δείγματα από πολυπροπυλένιο, ένα πλαστικό που φτιάχνει δοχεία, πλαστική μεμβράνη και άλλα μαλακά πλαστικά. To συγκεκριμένο υλικό δεν ανακυκλώνεται και, όπως και άλλα πλαστικά, χρειάζονται δεκαετίες για να περιοριστεί-διαλυθεί.
Αρχικά, τα πλαστικά θερμάνθηκαν και υποβλήθηκαν σε επεξεργασία τόσο με υπεριώδη ακτινοβολία, όσο και με το χημικό Fenton. Στη συνέχεια, «τροφοδοτήθηκαν» στους μύκητες και αφέθηκαν για 90 ημέρες. Μετά από 90 ημέρες, το πλαστικό περιορίστηκε κατά 27%. Μετά από 140 ημέρες, διαλύθηκε πλήρως.

Ο καθηγητής Ali Abbas, ο ερευνητής του πειράματος, σημείωσε στο ABC Net Australia, «Είναι το υψηλότερο ποσοστό ‘υποβάθμισης’ που αναφέρεται στη βιβλιογραφία που γνωρίζουμε στον κόσμο». Μέσα σε πέντε χρόνια, η ομάδα ελπίζει ότι οι μύκητες μπορούν να καταστρέψουν τις χωματερές σε όλη τη χώρα. “Είναι η κλιμάκωση που μοιάζει πολύ με κάθε είδους διαδικασία ζύμωσης“, συμπλήρωσε.

Photo: University of Sydney
Ο συγκεκριμένος τρόπος διαχείρισης αποβλήτων θα μπορούσε να είναι κομβικής σημασίας για απομονωμένες περιοχές που παράγουν απόβλητα αλλά δεν έχουν την υποδομή ή τον χώρο για στέγαση των απορριμμάτων.

Ωστόσο, είναι απαραίτητο ο κόσμος να μειώσει τη χρήση του πλαστικού, ακόμη και αν η πλήρης ‘καταστροφή’ του επιτευχθεί. Η παραγωγή πλαστικών, καθώς και η ανακύκλωση, παράγουν άνθρακα σε μεγάλες ποσότητες. Η “αποικοδόμηση” μέσω της μούχλας θα απελευθερώσει επίσης άνθρακα. Ενώ τέτοιες λύσεις είναι ιδιαίτερα πολύτιμες για τα υπάρχοντα απόβλητα, το πρώτο R στο“Reduce, Reuse, Recycle” (Μείωση, Επαναχρησιμοποίηση, Ανακύκλωση) εξακολουθεί να είναι το πιο πολύτιμο. Κοινώς πρέπει να περιορίσουμε τη χρήση πλαστικών ασχέτως εάν βρεθεί ο τρόπος να τα καταστρέφουμε μετά τη χρήση τους.